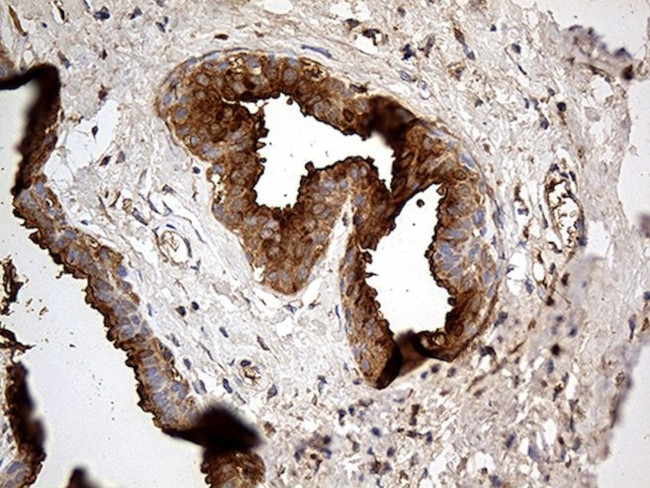
AZGP1 Antibody in Immunohistochemistry (Paraffin) (IHC (P))

Search
OriGene
AZGP1 Monoclonal Antibody (OTI2H3), TrueMAB™
{{$productOrderCtrl.translations['antibody.pdp.commerceCard.promotion.promotions']}}
{{$productOrderCtrl.translations['antibody.pdp.commerceCard.promotion.viewpromo']}}
{{$productOrderCtrl.translations['antibody.pdp.commerceCard.promotion.promocode']}}: {{promo.promoCode}} {{promo.promoTitle}} {{promo.promoDescription}}. {{$productOrderCtrl.translations['antibody.pdp.commerceCard.promotion.learnmore']}}
产品信息
TA812186
种属反应
宿主/亚型
分类
类型
克隆号
抗原
偶联物
形式
浓度
规格
纯化类型
保存液
内含物
保存条件
运输条件
靶标信息
Alpha-2-glycoprotein 1, zinc-binding (AZGP1) is a gene encoding a protein that belongs to the immunoglobulin superfamily. This protein is abundant in various body fluids, such as blood plasma and milk, and is involved in lipid mobilization. AZGP1 is expressed in numerous tissues, including the liver, prostate, and adipose tissue, where it plays a significant role in the regulation of lipid metabolism and adipocyte function. It acts as an adipokine, influencing the breakdown and mobilization of fats, thereby contributing to energy homeostasis. In cancer research, AZGP1 has been highlighted for its potential as a prognostic biomarker, particularly in prostate and breast cancer, where lower expression levels are often associated with poor prognosis. Recent studies have also linked AZGP1 to cachexia, an extreme form of weight loss and muscle wasting, by promoting lipid mobilization in adipose tissue and influencing systemic catabolic states. Due to its multifaceted roles in lipid metabolism and disease processes, AZGP1 is considered a promising target for therapeutic interventions in metabolic and cancer-related disorders.
仅用于科研。不用于诊断过程。未经明确授权不得转售。
篇参考文献 (0)
生物信息学
蛋白别名: Alpha-2-glycoprotein, zinc; testicular tissue protein Li 227; Zinc a 2 glycoprotein; Zinc a2glycoprotein; Zinc alpha2glycoprotein; Zinc α 2 glycoprotein; Zinc α2glycoprotein; Zinc-alpha-2-glycoprotein; Zn a 2 glycoprotein; Zn a 2 GP; Zn alpha 2 glycoprotein; Zn alpha 2 GP; Zn α 2 glycoprotein; Zn α 2 GP; zn-alpha-2-glycoprotein; Zn-alpha-2-GP; Zn-alpha2-glycoprotein
基因别名: AZGP1; ZA2G; ZAG; ZNGP1
UniProt ID: (Human) P25311
Entrez Gene ID: (Human) 563